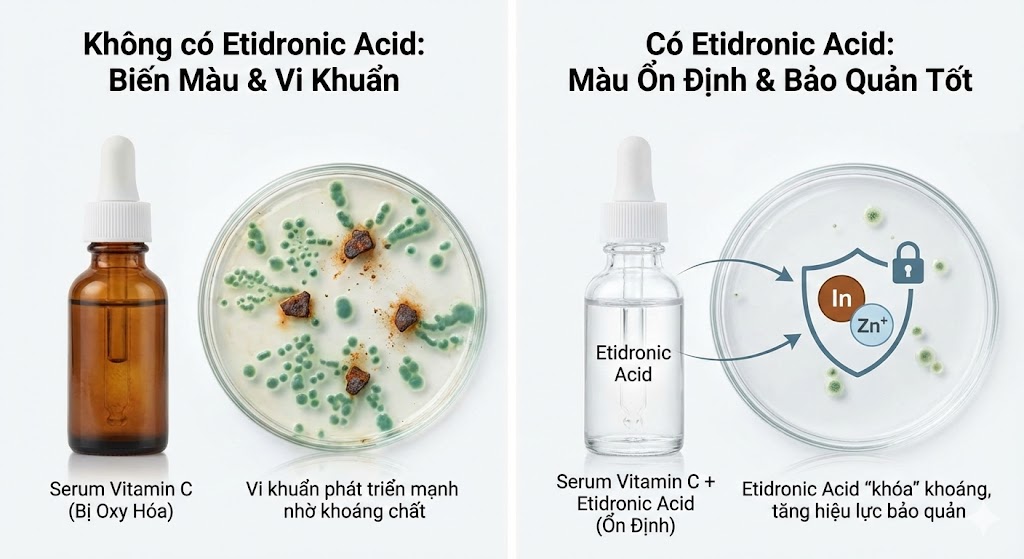

Tại Sao Mỹ Phẩm Bị Đổi Màu & Ôi Dầu? "Giải Mã" Kẻ Thù Vô Hình Và Sức Mạnh Của Chất Càng Hóa Etidronic Acid
Trong hành trình tạo ra những sản phẩm làm đẹp hoàn hảo, từ những bánh xà phòng handmade nghệ thuật cho đến những lọ kem dưỡng da cao cấp, có một cơn ác mộng mà bất kỳ nhà sản xuất nào cũng sợ hãi: Sự mất ổn định (Instability).
Bạn đã bao giờ rơi vào tình huống dở khóc dở cười này chưa:
-
Mẻ xà phòng tâm huyết, đắt tiền bỗng nhiên nổi những đốm màu cam xấu xí (DOS) và bốc mùi dầu hôi chỉ sau vài tuần lên kệ?
-
Lọ serum Vitamin C được quảng cáo là "trắng sáng" lại chuyển sang màu vàng nâu như nước chè trước khi khách kịp dùng hết?
-
Hay màu tóc nhuộm tại Salon không lên chuẩn tone, nhanh phai màu dù đã dùng thuốc xịn?
Đừng vội đổ lỗi cho tay nghề hay công thức của bạn. Rất có thể, thủ phạm là những "kẻ phá hoại thầm lặng" đang lẩn trốn ngay trong nguồn nước và nguyên liệu thô của bạn: Các Ion Kim Loại Nặng.
Hôm nay, hãy cùng đi sâu vào thế giới hóa học đằng sau sự ổn định của mỹ phẩm, và tìm hiểu tại sao Etidronic Acid (HEDP) lại được các chuyên gia R&D xem là "chìa khóa vàng" để bảo vệ sự tinh khiết cho sản phẩm.
1. Bản chất của vấn đề: Tại sao Ion Kim Loại lại nguy hiểm?
Để hiểu tại sao chúng ta cần Etidronic Acid, trước hết phải hiểu "kẻ thù" là ai.
Trong quá trình sản xuất, dù quy trình có sạch đến đâu, chúng ta vẫn khó tránh khỏi sự hiện diện của các ion kim loại vi lượng (Trace Metals) như Sắt (Fe3+), Đồng (Cu2+), Canxi (Ca2+), Magie (Mg2+), Mangan (Mn2+)... Chúng xâm nhập vào sản phẩm từ:
-
Nguồn nước: Nước máy, nước ngầm và đôi khi cả nước cất chưa đạt chuẩn.
-
Nguyên liệu thiên nhiên: Dầu thực vật, bơ hạt mỡ, chiết xuất thảo mộc, đất sét, bột màu khoáng... (Cây cối hấp thụ khoáng chất từ đất, nên trong dầu thực vật luôn có kim loại).
-
Thiết bị sản xuất: Sự mài mòn vi mô của bồn trộn, cánh khuấy kim loại.
Phản ứng dây chuyền chết người
Tuy hàm lượng cực nhỏ (tính bằng phần triệu - ppm), nhưng các ion kim loại này đóng vai trò là Chất xúc tác (Catalyst) cực mạnh cho các phản ứng oxy hóa khử.
-
Sắt và Đồng: Kích hoạt quá trình oxy hóa các liên kết đôi trong dầu béo, tạo ra các gốc tự do (Free Radicals). Đây là nguyên nhân trực tiếp gây ra mùi hôi dầu (Rancidity).
-
Canxi và Magie: Phản ứng với axit béo trong xà phòng tạo ra muối kết tủa không tan (Cặn xà phòng), làm giảm bọt và gây rít da.
Nếu không có biện pháp ngăn chặn, các ion này sẽ âm thầm phá hủy sản phẩm của bạn từ bên trong, bất chấp bạn có dùng bao nhiêu chất bảo quản đi chăng nữa.
2. Etidronic Acid là gì? Cơ chế "Chiếc Càng Cua" thần kỳ
Để vô hiệu hóa các ion kim loại, ngành hóa mỹ phẩm sử dụng một nhóm chất gọi là Chất càng hóa (Chelating Agent). Cái tên này bắt nguồn từ chữ Hy Lạp "Chele" - nghĩa là "Càng cua".
Etidronic Acid, tên hóa học đầy đủ là 1-Hydroxyethylidene-1,1-Diphosphonic Acid (viết tắt: HEDP), là một trong những chất càng hóa hữu cơ mạnh mẽ nhất thuộc nhóm Bisphosphonate.
Cơ chế hoạt động
Hãy tưởng tượng phân tử Etidronic Acid giống như một con cua có hai chiếc càng lớn. Khi gặp các ion kim loại tự do (như ion Sắt đang lơ lửng trong kem dưỡng), Etidronic Acid sẽ dùng càng "kẹp chặt" lấy ion đó, bao bọc và cô lập nó hoàn toàn khỏi môi trường xung quanh.
Phức hợp mới tạo thành (giữa Etidronic Acid và Kim loại) rất bền vững, tan trong nước và trơ về mặt hóa học.
Kết quả: Ion kim loại bị "giam lỏng", không còn khả năng xúc tác cho các phản ứng oxy hóa phá hoại nữa.
Etidronic Acid (HEDP) khác gì với EDTA?
Nhiều người sẽ hỏi: "Tại sao tôi không dùng EDTA cho rẻ mà phải dùng Etidronic Acid?". Câu trả lời nằm ở tính năng vượt trội:
-
Độ ổn định nhiệt: Etidronic Acid chịu được nhiệt độ cao hơn nhiều so với EDTA. Điều này cực kỳ quan trọng trong quy trình làm xà phòng nóng (Hot Process) hoặc các sản phẩm cần gia nhiệt.
-
Khả năng chống oxy hóa: Trong môi trường có chất oxy hóa mạnh (như Thuốc nhuộm tóc, Kem tẩy chứa Oxy già), EDTA dễ bị phá vỡ, còn Etidronic Acid vẫn hoạt động bền bỉ.
-
Hoạt động trong pH rộng: HEDP hoạt động hiệu quả trong dải pH rộng hơn, đặc biệt ổn định trong môi trường kiềm cao của xà phòng.
3. Ứng dụng thực tế 1: "Cứu Tinh" Cho Xà Phòng (Soap Making)
Nếu bạn là một người làm xà phòng (Soap Maker), chắc hẳn bạn đã nghe đến nỗi ám ảnh mang tên DOS (Dreaded Orange Spots) - Những đốm cam đáng sợ.
Nguyên nhân của DOS
DOS thực chất là các điểm dầu bị ôi thiu cục bộ. Khi bạn làm xà phòng với độ dư dầu (Superfat) để dưỡng da, lượng dầu dư này rất dễ bị oxy hóa. Chỉ cần một lượng nhỏ ion kim loại có trong tinh dầu hoặc nước sẽ kích hoạt phản ứng này, tạo ra các đốm màu cam/nâu và mùi hôi khó chịu.
Giải pháp từ Etidronic Acid
Thêm Etidronic Acid vào quy trình làm xà phòng (thường là 0.1% - 0.5% vào dung dịch kiềm) mang lại 3 lợi ích vàng:
-
Chặn đứng DOS: Khóa chặt kim loại, ngăn chặn quá trình oxy hóa dầu. Bánh xà phòng giữ được màu sắc tươi sáng, không bị đốm cam dù để cả năm trời.
-
Bảo vệ mùi hương: Tinh dầu nước hoa rất nhạy cảm. HEDP giúp ổn định cấu trúc hương liệu, giúp bánh xà phòng thơm lâu và "tròn vị" hơn, không bị biến đổi mùi.
-
Tăng bọt trong nước cứng: HEDP bắt lấy Canxi/Magie trong nước máy, giúp xà phòng tạo bọt bông mịn, không tạo váng cặn (Scum) bám trên bồn rửa mặt.

4. Ứng dụng thực tế 2: Bí mật của Salon Tóc (Hair Care)
Trong các Salon chuyên nghiệp, Etidronic Acid là thành phần không thể thiếu nhưng ít ai để ý trong các chai Oxy trợ nhuộm (Developer) và Dầu gội.
Ổn định Oxy già (Peroxide Stabilizer)
Thuốc nhuộm tóc hoạt động dựa trên Hydrogen Peroxide (H2O2). Chất này rất kém bền, dễ bị phân hủy thành nước và khí oxy nếu gặp kim loại.
Nếu chai Oxy trợ nhuộm của bạn không có chất ổn định, nó sẽ nhanh chóng mất tác dụng ("bay hơi"). Khi thợ pha thuốc, nồng độ oxy không còn chuẩn, dẫn đến màu tóc lên không đều hoặc không lên màu. Etidronic Acid được thêm vào để giữ cho Oxy luôn ổn định nồng độ.
Khóa màu tóc & Ngăn ngừa hư tổn
Nước sinh hoạt chứa nhiều kim loại (đặc biệt là Đồng). Kim loại tích tụ trên tóc sẽ phản ứng dữ dội với thuốc nhuộm, gây ra phản ứng tỏa nhiệt làm tóc khô xơ, gãy rụng và làm lệch màu nhuộm (đặc biệt là các màu thời trang như Khói, Bạch kim).
Các loại dầu gội "thải độc" (Clarifying Shampoo) chứa Etidronic Acid giúp bóc tách lớp kim loại bám trên tóc, giúp tóc sạch, khỏe và ăn màu nhuộm chuẩn xác hơn.

5. Ứng dụng thực tế 3: "Vệ sĩ" cho Kem Dưỡng & Lotion (Skincare)
Trong mảng chăm sóc da (Skin Care), xu hướng hiện nay là sử dụng các hoạt chất "Active" mạnh mẽ như Vitamin C, Retinol, Kojic Acid, Peptide... Tuy nhiên, các chất này lại cực kỳ "đỏng đảnh" và dễ bị phân hủy.
Ngăn ngừa biến màu (Discoloration)
Chỉ một lượng siêu nhỏ ion Sắt cũng có thể làm Serum Vitamin C chuyển màu vàng sậm và mất tác dụng. Etidronic Acid hoạt động như một lớp khiên bảo vệ, giúp hệ nền của kem/serum ổn định màu sắc và độ trong suốt.
Tăng hiệu lực chất bảo quản (Preservative Booster)
Đây là một công dụng ít người biết. Vi khuẩn và nấm mốc cần các vi khoáng chất (Sắt, Kẽm...) để sinh sôi và xây dựng màng tế bào.
Bằng cách tước đoạt các ion kim loại này, Etidronic Acid gián tiếp làm vi khuẩn bị "suy dinh dưỡng" và yếu đi. Nhờ đó, các chất bảo quản chính trong công thức sẽ tiêu diệt vi khuẩn dễ dàng hơn. Điều này cho phép nhà sản xuất giảm bớt nồng độ chất bảo quản hóa học, giúp sản phẩm an toàn hơn cho da nhạy cảm.
6. Hướng dẫn sử dụng Etidronic Acid trong công thức
Etidronic Acid thường được bán dưới dạng dung dịch lỏng (thường là nồng độ 60%), trong suốt hoặc vàng nhạt, rất dễ hòa tan và phối trộn.
Tỷ lệ sử dụng tham khảo:
-
Xà phòng (CP/HP/Melt & Pour): 0.1% – 0.5% (tính trên tổng lượng dầu). Thêm vào nước trước khi pha kiềm hoặc thêm vào lúc Trace.
-
Dầu gội, Sữa tắm: 0.1% – 0.3%. Thêm vào pha nước (Water phase).
-
Kem dưỡng, Lotion, Toner: 0.05% – 0.2%.
-
Thuốc nhuộm tóc: 0.1% – 1.0%.
Lưu ý quan trọng:
Etidronic Acid có tính axit (pH thấp).
-
Trong xà phòng (môi trường kiềm cao): Nó tự trung hòa và hoạt động tốt.
-
Trong kem dưỡng/dầu gội (pH trung tính 5.5 - 6.0): Khi thêm HEDP vào, pH của sản phẩm sẽ giảm xuống. Bạn cần sử dụng chất kiềm (như Triethanolamine - TEA hoặc dung dịch NaOH loãng) để chỉnh pH về mức mong muốn.
7. Kết luận: Sự đầu tư nhỏ cho Chất lượng lớn
Trong thị trường mỹ phẩm ngày càng khắt khe, người tiêu dùng không chỉ đòi hỏi sản phẩm có tác dụng tốt mà còn phải Đẹp - Thơm - Bền.
Sự xuất hiện của những đốm màu lạ, mùi hôi hay sự tách lớp là dấu chấm hết cho uy tín của thương hiệu.
Việc bổ sung Etidronic Acid (HEDP) vào công thức không làm tăng chi phí sản xuất đáng kể (vì tỷ lệ dùng rất thấp), nhưng nó mang lại sự an tâm tuyệt đối về độ ổn định. Nó là minh chứng cho thấy sản phẩm của bạn được nghiên cứu kỹ lưỡng và sản xuất chuyên nghiệp chứ không phải là sự pha trộn ngẫu hứng.
Nếu bạn đang tìm kiếm giải pháp để nâng tầm chất lượng sản phẩm, hãy bắt đầu từ việc kiểm soát nguồn kim loại trong công thức ngay hôm nay.
Mua Etidronic Acid (HEDP) Chuẩn Mỹ Phẩm Ở Đâu?
Để đảm bảo hiệu quả tối ưu, việc lựa chọn nguồn nguyên liệu tinh khiết, đúng hàm lượng là vô cùng quan trọng. Hàng công nghiệp trôi nổi có thể lẫn tạp chất gây hại cho da.
Hóa Chất Nam Hà tự hào là đơn vị nhập khẩu và phân phối trực tiếp Etidronic Acid (HEDP) chất lượng cao, có đầy đủ giấy tờ kiểm định (COA, MSDS), phục vụ cho hàng trăm đối tác là các Xưởng sản xuất mỹ phẩm, Phòng Lab và Cộng đồng làm xà phòng Handmade tại Miền Tây.
-
Chúng tôi cung cấp: Hàng nguyên đai nguyên kiện hoặc chiết lẻ can nhỏ cho các đơn vị R&D.
-
Tư vấn kỹ thuật: Hỗ trợ công thức và cách sử dụng chi tiết.
Tham khảo thông tin chi tiết sản phẩm và đặt hàng tại đây:
